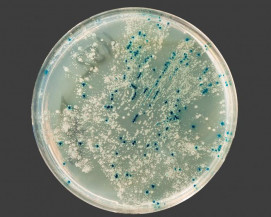

Статьи
Подбор аспираторов для проведения санитарно-микробиологического исследования воздуха
Рекомендации по выбору аспиратора (импактора) для проведения санитарно-микробиологического исследования воздуха
Какой аспиратор с поверкой купить для проведения санитарно-микробиологического исследования воздуха?
 Задачами санитарно-микробиологического исследования воздуха являются гигиеническая и эпидемиологическая оценка воздушной среды, и, как следствие, разработка комплекса мероприятий, направленных на профилактику аэрогенной передачи возбудителей инфекционных болезней.
Задачами санитарно-микробиологического исследования воздуха являются гигиеническая и эпидемиологическая оценка воздушной среды, и, как следствие, разработка комплекса мероприятий, направленных на профилактику аэрогенной передачи возбудителей инфекционных болезней.
Объектами санитарно-микробиологического исследования воздуха закрытых помещений являются:
- воздух больниц (операционные, отделение реанимации, родильные залы роддомов, и т.п.);
- воздух детских садов, школ;
- воздух поликлиник, аптек;
- воздух производственных цехов и вспомогательных помещений на предприятиях различного профиля (пищевых, микробного синтеза и т.п.);
- воздух мест массового скопления людей -кинотеатров, спортивных залов и т. д.
При изучении присутствия микроорганизмов различных физиологических групп в воздухе используют питательные среды разного назначения (как стандартные, так и элективные или дифференциально-диагностические), в зависимости от цели исследования.
Санитарно-микробиологическое исследование воздуха можно разделить на 4 этапа:
- отбор проб;
- обработка, транспортировка, хранение проб, получение концентрата микроорганизмов (если необходимо);
- бактериологический посев, культивирование микроорганизмов;
- идентификация выделенной культуры.
Отбор проб, как и при исследовании любого объекта, является наиболее ответственным. Правильное взятие проб гарантирует точность исследования. В закрытых помещениях точки отбора проб устанавливаются из расчета на каждые 20 м2 площади — одна проба воздуха, по типу конверта: 4 точки по углам комнаты (на расстоянии 0,5 м от стен) и 5-я точка — в центре. Пробы воздуха забираются на высоте 1,6—1,8 м от пола — на уровне дыхания в жилых помещениях. Пробы необходимо отбирать днем (в период активной деятельности человека), после влажной уборки и проветривания помещения. Атмосферный воздух исследуют в жилой зоне на уровне 0,5—2 м от земли вблизи источников загрязнения, а также в зеленых зонах (парки, сады и т.д.) для оценки их влияния на микрофлору воздуха. Для отбора воздуха на уровне 0,5-2м от земли используют специальные штативы.
Следует обратить внимание на то, что при отборе проб воздуха во многих случаях происходит посев его на питательную среду.
РЕКОМЕНДУЕМЫЙ АСПИРАТОР ДЛЯ ПРОВЕДЕНИЯ САНИТАРНО-МИКРОБИОЛОГИЧЕСКОГО ИССЛЕДОВАНИЯ ВОЗДУХА:
Все методы отбора проб воздуха можно разделить на седиментационные и аспирационные.
Седиментационный — наиболее старый метод, широко распространен благодаря простоте и доступности, однако является неточным. Метод предложен Р. Кохом и заключается в способности микроорганизмов под действием силы тяжести и под влиянием движения воздуха (вместе с частицами пыли и капельками аэрозоля) оседать на поверхность питательной среды в открытые чашки Петри. Чашки устанавливаются в точках отбора на горизонтальной поверхности. При определении общей микробной обсемененности чашки с мясопептонным агаром оставляют открытыми на 5—10 мин или дольше в зависимости от степени предполагаемого бактериального загрязнения. Для выявления санитарно-показательных микробов применяют среду Гарро или Туржецкого (для обнаружения стрептококков), молочно-солевой или желточно-солевой агар (для определения стафилококков), суслоагар или среду Сабуро (для выявления дрожжей и грибов). При определении санитарно- показательных микроорганизмов чашки оставляют открытыми в течение 40—60 мин.
По окончании экспозиции все чашки закрывают, помещают в анаэростат или термостат для культивирования в оптимальной для развития выделяемого микроорганизма среде, затем (если этого требуют исследования) на 48 ч оставляют при комнатной температуре для образования пигмента пигментообразующими микроорганизмами.
Седиментационный метод имеет ряд недостатков: на поверхность среды оседают только грубодисперсные фракции аэрозоля; нередко колонии образуются не из единичной клетки, а из скопления микробов; на применяемых питательных средах вырастает только часть воздушной микрофлоры. К тому же этот метод совершенно непригоден при исследовании бактериальной загрязненности атмосферного воздуха.
Более совершенными методами являются аспирационные, основанные на принудительном осаждении микроорганизмов из воздуха на поверхность плотной питательной среды или в улавливающую жидкость (мясо-пептонный бульон, буферный раствор, изотонический раствор хлорида натрия и др.). В практике санитарной службы при аспирационном взятии проб используются аппарат Кротова, пробоотборное устройство ПУ-1Б, бактериоуловитель Речменского, прибор для отбора проб воздуха (ПОВ-1), пробоотборник аэрозольный бактериологический (ПАБ-1), бактериально-вирусный электропреципитатор (БВЭП-1), прибор Киктенко, приборы Андерсена, Дьяконова, МБ и др. Для исследования атмосферы могут быть использованы и мембранные фильтры № 4, через которые воздух просасывается с помощью аппарата Зейтца. Большое разнообразие приборов свидетельствует об отсутствии универсального аппарата и о большей или меньшей степени их несовершенства.
Купить ПУ-1Б — пробоотборное устройство (импактор) для отбора воздушной пробы
В настоящее время этот прибор широко применяется при исследовании воздуха закрытых помещений и имеется в лабораториях СЭС.
П ринцип работы ПУ-1Б основан на том, что воздух, просасываемый через отверстия в крышке аппарата, ударяется о поверхность питательной среды, при этом частицы пыли и аэрозоля прилипают к среде, а вместе с ними и микроорганизмы, находящиеся в воздухе. Чашку Петри с тонким слоем среды укрепляют на вращающемся столике аппарата, что обеспечивает равномерное распределение бактерий на ее поверхности. Работает аппарат от электросети. После отбора пробы с определенной экспозицией чашку вынимают, закрывают крышкой и помещают на 48 ч в термостат. Обычно отбор проб проводят со скоростью 200 л/мин в течение 0,5-5 мин. Таким образом, определяется флора в 100-1000 л воздуха.
ринцип работы ПУ-1Б основан на том, что воздух, просасываемый через отверстия в крышке аппарата, ударяется о поверхность питательной среды, при этом частицы пыли и аэрозоля прилипают к среде, а вместе с ними и микроорганизмы, находящиеся в воздухе. Чашку Петри с тонким слоем среды укрепляют на вращающемся столике аппарата, что обеспечивает равномерное распределение бактерий на ее поверхности. Работает аппарат от электросети. После отбора пробы с определенной экспозицией чашку вынимают, закрывают крышкой и помещают на 48 ч в термостат. Обычно отбор проб проводят со скоростью 200 л/мин в течение 0,5-5 мин. Таким образом, определяется флора в 100-1000 л воздуха.
Приемник перед забором пробы воздуха заполняется 3—5 мл улавливающей жидкости (водой, мясопептонным бульоном, изотоническим раствором хлорида натрия).
При использовании импакторов получаемые результаты являются приблизительными, однако они дают более правильную оценку обсемененности воздуха в сравнении с седиментационным методом. Поскольку и отбор и санитарно-микробиологические исследования воздуха не регламентированы ГОСТ, то можно использовать любой прибор для оценки бактериальной загрязненности воздуха. Во многих случаях отбор проб совмещен с этапом посева.
Для снижения численности микроорганизмов в воздухе закрытых помещений применяют следующие средства:
- химические — обработка озоном, двуокисью азота, распыление молочной кислоты,
- механические — пропускание воздуха через специальные фильтры,
- физические — ультрафиолетовое облучение.
Определение общей численности сапрофитных бактерий
Общая бактериальная обсемененность воздуха или микробное число — это суммарное количество микроорганизмов, содержащихся в 1 м3 воздуха. Для определения общего количества бактерий в воздухе закрытых помещений забирают две пробы (объемом по 100 л каждая) на чашки Петри с МПА при помощи Пу-1Б, либо седиментационным методом, расставляя чашки с питательной средой по принципу конверта. Чашки с посевом помещают в термостат на сутки, а затем на 48 ч оставляют при комнатной температуре. Экспозиция чашек с посевами на свету дает возможность подсчитать раздельно количество пигментных колоний (желтых, белых, розовых, черных, оранжевых и др.), количество спорообразующих бацилл, грибов и актиномицетов.
Общая бактериальная обсемененность воздуха или микробное число — это суммарное количество микроорганизмов, содержащихся в 1 м3 воздуха. Для определения общего количества бактерий в воздухе закрытых помещений забирают две пробы (объемом по 100 л каждая) на чашки Петри с МПА при помощи Пу-1Б, либо седиментационным методом, расставляя чашки с питательной средой по принципу конверта. Чашки с посевом помещают в термостат на сутки, а затем на 48 ч оставляют при комнатной температуре. Экспозиция чашек с посевами на свету дает возможность подсчитать раздельно количество пигментных колоний (желтых, белых, розовых, черных, оранжевых и др.), количество спорообразующих бацилл, грибов и актиномицетов.
Подсчитывают количество колоний на обеих чашках, вычисляют среднее арифметическое и делают перерасчет на количество микроорганизмов в 1 м3 воздуха. Бациллы образуют колонии, как правило, крупные, круглые, с неровными краями, сухие, морщинистые. Колонии грибов с пушистым налетом (Мисог и Aspergillus) и плотные — зеленоватые или сероватые (Penicillium). Актиномицеты образуют беловатые колонии, вросшие в агар. Количество каждой группы колоний (пигментных, беспигментных, плесеней, бацилл, актиномицетов) выражают в процентах по отношению к общему числу.
При определении микробного числа методом седиментации по Коху подсчитываются колонии, выросшие на МПА в чашках Петри, и расчет ведется по B.Л. Омелянскому. Если придерживаться этой методики, на чашку площадью 100 см2 за 5 мин оседает такое количество микробов, которое содержится в 10 л воздуха.
Определение стафилококков
Стафилококки являются одним из наиболее распространенных микроорганизмов в воздухе закрытых помещений, что обусловливается значительной устойчивостью их к различным факторам окружающей среды. Обнаружение патогенных стафилококков в воздухе закрытых помещений имеет санитарно-показательное значение и свидетельствует об эпидемическом неблагополучии. Отбор проб воздуха проводится в количестве 250 л на 2—3 чашки с молочно-желточно-солевым агаром (или молочно- солевым, желточно-солевым) и на чашку с кровяным агаром. Чашки инкубируют при температуре 37°С в течение 48 ч. Изучают культуральные признаки всех видов колоний, из подозрительных готовят мазки и окрашивают по Граму.
Помимо качественной характеристики отдельных колоний, подсчитывают количество выросших колоний стафилококков в 1 м3 воздуха.
Определение стрептококков
Стрептококки также являются санитарно-показательными микроорганизмами воздуха, в который они попадают от больных скарлатиной, тонзиллитами, ангиной и носителей стрептококков. Отбор проб воздуха при исследовании на наличие а- и р-гемолитических стрептококков производят на чашки с кровяным агаром, средами Гарро и Туржецкого. Забирают 200—250 л воздуха, чашки с посевами выдерживают в термостате 18—24 ч и затем еще 48 ч при комнатной температуре (после предварительного просмотра и учета). Идентификацию проводят по общепринятой методике.
Определение патогенных микроорганизмов в воздухе
Ввиду малой концентрации патогенных микроорганизмов в воздухе закрытых помещений, их выделение является достаточно трудной задачей.
При расшифровке внутрибольничных инфекций определяют в воздухе присутствие стафилококков, стрептококков, синегнойной палочки, сальмонелл, протеев и др. Отбор проб воздуха производят в объеме не менее 1000 л. Посев производят на соответствующие элективные среды. Если используется жидкая среда как улавливающая жидкость, то пробирку с жидкостью помещают в термостат на сутки для подращивания (получение накопительной культуры), а затем высевают на элективную среду.
При исследовании воздуха на наличие микобактерий туберкулеза отбор проб производят в объеме 250—500 л воздуха. В качестве улавливающей жидкости берут среду Школьниковой, которую затем обрабатывают 3% раствором серной кислоты (для подавления сопутствующей микрофлоры) и центрифугируют. Осадок засевают в пробирки на одну из яичных сред, чаще среду Левенштейна — Иенсена. Инкубируют при 37°С до 3 мес. Отсутствие роста в течение 3 мес дает возможность выдать отрицательный ответ. Пробирки первый раз просматривают через 3 нед, затем каждые 10 дней. Выделенную культуру идентифицируют, определяют ее вирулентность (заражением морских свинок — биопроба) и при необходимости определяют устойчивость к лекарственным препаратам.
При определении в воздухе коринебактерий дифтерии для посева воздуха используют чашки со средой Клауберга.
В последние годы определяют в атмосферном воздухе в районах дождевания земледельческих полей, при орошении их сточными водами, сальмонеллы в случае появления заболевания среди персонала станций орошения или населения. Отбор проб производят с помощью аспиратора ПУ-1Б на чашки с висмут-сульфитным агаром. Исследуют не менее 200 л воздуха. Выделенная культура идентифицируется по обычной схеме определения сальмонелл.
В связи с развитием микробиологической промышленности возникла необходимость исследования воздуха с целью обнаружения грибов-продуцентов при производстве антибиотиков, ферментных препаратов, при изготовлении кормовых дрожжей и др. Для исследования воздуха на плесневые грибы рода Candida отбор проб производят в объеме от 100 до 1000 л на чашки со средой Чапека, суслоагаром (для обнаружения плесневых грибов) и с метабисульфит-натрий- агаром (МБС-агар) с добавлением антибиотиков (для обнаружения дрожжеподобных грибов рода Candida). Чашки инкубируют в термостате при температуре 26—27°С в течение 3—4 сут (для плесневых грибов) и при 35—37°С в течение 2—3 сут (для грибов — продуцентов и дрожжеподобных рода Candida). Идентификация проводится с учетом особенностей плодоносящих гиф и характера мицелия. Считают, что концентрация дрожжеподобных грибов в количестве 500—600 клеток в 1 м3 воздуха рабочего помещения является предельной, превышение ее ведет к развитию аллергических реакций у рабочих.
Описание работы с аспиратором ПУ-1Б и способ расчета концентрации микроорганизмов








